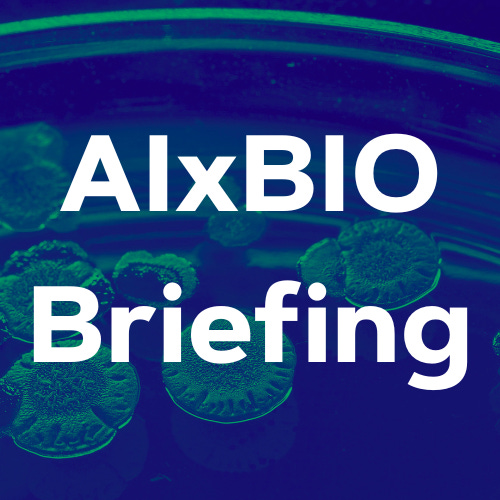
AIxBio Briefing

Molecular Meditations
Sofya Lebedeva, Garrett Ehinger, Jo Duyvestyn, TheBathBiologist | SofiiaMusings on bioinformatics, immunology, running and trying to do good in the world. Come for the science, stay for the training updates and various shiny links that I find.
| Platform | Pricing | Only free issues | Publishes | Weekly | |
|---|---|---|---|---|---|
| Issues | 40 | Subscribers | Read | sofyalebedeva.substack.com |
Curious about how many subscribers Molecular Meditations has or want to find similar newsletters? Reletter has got you covered. We collated all the information we could find from across the web in our database of over three million newsletters.
Check the email archives, get traffic estimates, engagement scores and more to discover the best advertising opportunities.
Our search tool helps you locate relevant newsletters for any topic and compare their stats for better sponsorship decisions.
Latest Issues
Recent posts by this newsletter. Browse the email archive.
Wet Lab 101 - Part 2
Last updated: 18/09/2025
Why Sanitation Matters for Global Health and Pandemic Preparedness
Authors: Sofya Lebedeva and Sofiia Furman
So I qualified for the world champs ...
TL:DR: Sports are finally moving off this Substack and into their own newsletter. No action is needed from you if you are only interested in the science work that I do.
Wet Lab 101 - Part 1
Last updated: 17/09/2025
Similar Newsletters
Other publications recommended by the authors of this newsletter.
Authors
The writers behind this newsletter.
\ud83c\uddf7\ud83c\uddfa\ud83c\uddec\ud83c\udde7 Biosecurity, Immunology, Statistical genomics. I write about my PhD and my policy work here. For updates on my triathlon racing, please check out Triathlon Systems.
Biosecurity and Regulatory Policy Analyst
Virologist interested in preventing pandemics, improving global health and equity, and all things science.
linktr.ee/thebathbiologist Disability | Neurodiversity | Animals | Musicals | Biology | STEM \ud83c\udff3️\ud83c\udf08\ud83c\udff3️⚧️ \ud83e\udef6\ud83c\udfff♿\ud83d\udc89
Frequently Asked Questions
How can I access the email archive for Molecular Meditations?
You can find recent issues that have been published by Molecular Meditations on Reletter by scrolling up to where it says Latest Issues. Tap on the link for any of the most recent emails or hit More Issues to see older ones.
How many subscribers does Molecular Meditations have?
To see how many people subscribe to Molecular Meditations, simply upgrade your Reletter account. We provide readership numbers and lots of other stats for this newsletter so you can decide if it's worth reaching out to.
How can I advertise in Molecular Meditations?
Newsletter advertising can be extremely effective when it's done right. Before you pitch Molecular Meditations as a potential sponsor or partner, make sure that you've done your research and checked its newsletter stats with Reletter.
Then, personalize one of our winning pitching templates and send it to the right person using the contact info provided.
How much does it cost to sponsor a publication like Molecular Meditations?
Newsletter ad rates (or CPM) vary depending on many factors, including industry, number of subscribers, open rate, ad placement and more.
To find out how much an ad will cost, contact Molecular Meditations using the contact information provided and ask for a copy of their media kit.
How can I find newsletters similar to Molecular Meditations?
Scroll up to where it says Similar Newsletters to see other publications like Molecular Meditations. You can also search our email newsletter directory to discover other newsletters that cover the topics you're interested in.
How do I contact Molecular Meditations?
Reletter provides this newsletter's website URL above, where you will often find their contact information. We also provide links to associated social media accounts and pitching templates so you can reach out fast.